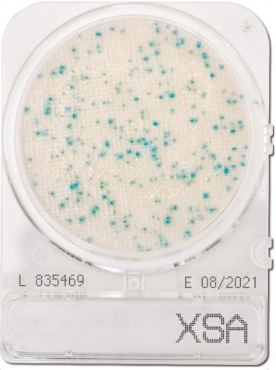
ĐĨA COMPACT DRY KIỂM TRA STAPHYLOCOCCUS AUREUS - XSA

Giá:
Đĩa Compact Dry kiểm tra Staphylococcus Aureus | Staphylococcus Aureus X-SA | Nissui
✅ Hãng sản xuất: Nissui – Nhật Bản
✅ Quy cách đóng gói: 4 đĩa/gói
✅ Nhiệt độ ủ: 35 ± 2°C
✅ Thời gian ủ: 24 ± 2 giờ
✅ Màu sắc khuẩn lạc: Màu xanh/màu xanh sáng.
Sản phẩm được chứng nhận của các tổ chức AOAC, MicroVal, NordVal.
- Staphylococcus Aureus còn được gọi là tụ cầu vàng, là một loài tụ cầu khuẩn Gram-dương kỵ khí, và là nguyên nhân thông thường nhất gây ra nhiễm khuẩn trong các loài tụ cầu, nó là hệ vi sinh vật phổ biến ở người, nó có thể được tìm thấy tự nhiên trên da, mũi và tóc. Do đó, Staphylococcus thường được sử dụng làm chỉ số vệ sinh cá nhân của người xử lý thực phẩm. Chúng thường vô hại nhưng với mật độ cao, Staphylococcus có thể bắt đầu hình thành nội độc tố gây ra tình trạng ngộ độc thực phẩm. Chúng cũng có thể chịu được hoạt độ nước thấp và ẩn chứa trong các thực phẩm nhiều đường.
Vì lẽ đó, quy trình kiểm nghiệm và phát hiện Staphylococcus Aureus được khuyến nghị, và đĩa Compact Dry Staphylococcus Aureus mang đến sự tiện lợi cho người sử dụng bởi ưu điểm không cần chuẩn bị hóa chất môi trường, dụng cụ, vật tư tiêu hao phức tạp. Tất cả công nghệ được sử dụng cho đĩa Compact Dry Staphylococcus Aureus này là môi trường được đổ sẵn. Và người sử dụng chỉ cần trích ly mẫu, nhỏ mẫu vào đĩa và đem đi ủ.
- Quy trình đơn giản dễ sử dụng, không cần chuẩn bị vật tư tiêu hao hay thiết bị phức tạp.
- Dễ dàng sử dụng và không mất thời gian đào tạo người sử dụng.
- Đĩa compact dry có thể bảo quản dễ dàng nhờ quy cách đóng gói 4 đĩa 1 gói.
- Kết quả khá chính xác, dễ phân tích và có kết quả sau 24 giờ.
- Có thể tách lấy khuẩn lạc để test sinh hóa.
- Cân vô trùng 10,0g mẫu hoặc dùng pippette lấy 10,0ml (đối với mẫu là dung dịch) cho vào dụng cụ vô trùng thích hợp (ví dụ như túi tiệt trùng đựng mẫu, chai pha loãng, túi Whirl Park).
- Thêm 90,0ml chất pha loãng để đạt được độ pha loãng 1:10 và đem đi đồng nhất mẫu. Điều chỉnh pH nếu cần thiết. Chất pha loãng được đề xuất thông thường là dung dịch đệm phosphate của Butterfield, chất pha loãng phục hồi tối đa và các chất pha loãng thích hợp khác tùy thuộc vào BAM.
- Nếu cần, có thể pha loãng mẫu hơn nữa.
- Mở nắp đĩa Compact Dry. Lấy 1,0ml mẫu pha loãng bằng micropipette, cho vào giữa đĩa Compact Dry. Đóng nắp đĩa lại.

- Đảo ngược và ủ đĩa compact dry ở điều kiện ủ cụ thể (Theo tiêu chuẩn AOAC International: 35 ± 2°C cho 24 ± 2 giờ, theo tiêu chuẩn Microval và NordVal: 37 ± 1°C cho 24 ± 2 giờ )
- Đọc kết quả
Mọi thông tin chi tiết vui lòng liên hệ
CÔNG TY TNHH GIẢI PHÁP CÔNG NGHỆ GIA LONG
Địa chỉ: 129/43/14/1 Liên Khu 5-6, Phường Bình Tân, Thành phố Hồ Chí Minh, Việt Nam
Hotline: 038.999.3000
Email: info@gialonglab.com
Website: gialonglab.com